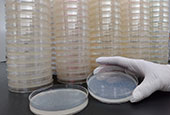

業種別ソリューション
製薬会社の皆さまへ

従来医療から個々の患者さんの遺伝情報にアプローチする「個別化医療」が求められる中、医薬品開発におけるBMLへのお客様ニーズも変化しています。
翌朝報告の治験専用検査室での安全性検査に加え、遺伝子変異解析(PCR)、免疫組織染色(IHC)、フローサイトメトリー(FCM)、マルチPlex(サイトカイン等)、PBMC分離、DNA抽出、各種バイオマーカーのGxP適合検査体制で医薬品開発をサポートします。

BMLは、創業以来培ってきた先進かつ高度な臨床検査技術と豊富なノウハウを基盤に、業界一を誇る営業・ラボ・システムの3つのネットワークを構築してまいりました。これらのネットワークを有効に機能させることで、全国の医療機関からの幅広い検査ニーズにお応えしています。

BMLでは、医薬品メーカーの新薬開発に伴う臨床検査に対応しています。
全国の集配ネットワークと治験専門の検査体制で、医薬品開発をサポートします。
BMLでは、一般化学物質や医薬品等の新規化学物質の製造・輸入承認を得るために必要な短期毒性試験である、変異原性試験(遺伝毒性試験)を実施しています。


